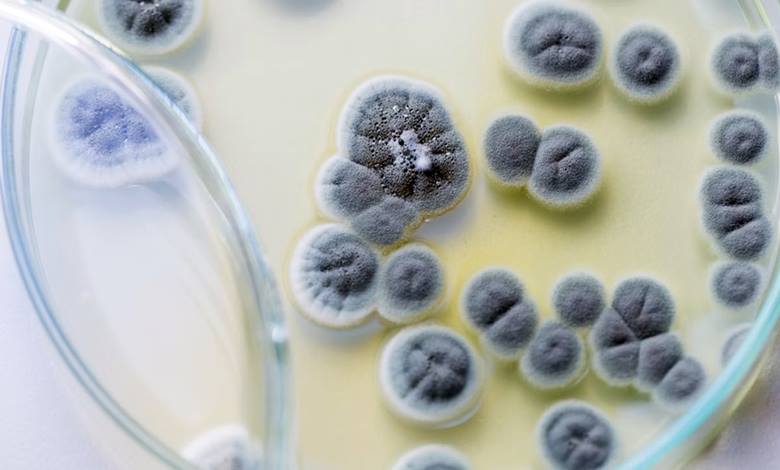

Yüzyıldan daha uzun bir süre yanan bir ampul mümkün mü? Ya da bir otomobili çekecek dayanıklılıkta bir kadın çorabı? Hatta…
Sibel Çağlar
Prag Astronomik Saat Kulesi ( Prag Orloj) Çek Cumhuriyeti’nin başkenti Prag’da, Eski Şehir Meydanı’nda yer alan ve hem tarihi hem…
Hayatımız boyunca birçok şey öğreniriz, ancak bunların büyük bir kısmını hızla unuturuz. Bu unutulan bilgiler arasında genellikle matematik becerileri de…
Dünya liderleri yüzyıllar boyunca güçlerini sergilemek için kırmızı kıyafetler giydiler. Günümüzde bile dünya bayraklarının yüzde 74’ünde kırmızı renk karşımıza çıkar.…
15. yüzyıla ait olduğu düşünülen Voynich El Yazması, dilbilim açısından hâlâ çözülememiş bir muamma olarak kabul edilir. Keşfedildiği ilk günden…
Günümüzde penisilinin keşfi, İskoç bakteriyolog Sir Alexander Fleming’in (1881-1955) adıyla birlikte anılır. Oysa Fleming’in keşfinden önce çok sayıda bilim insanının…
7, 13 gibi asal sayılar için bölünebilme kuralları okullarda öğretilmez. Genellikle bu sayıların kurallarının “zor” olduğu gerekçe olarak gösterilir. Ancak…
Günümüzde insanların safça basit yalanlara kolaylıkla inandıklarını düşünüyorsanız yanılıyorsunuz. Aslına bakarsanız 19. yüzyılın ortalarında, bir gazete editörü The Great Moon…
2023 yılı Nisan ayında İspanyol atlet Beatriz Flamini bir mağarada 500 gün kaldıktan sonra gün ışığına çıktı. Aynı zamanda da…
Gurudev adı ile de bilinen Hindistanlı Rabindranath Tagore (1861-1941) dünyada “Nobel Ödülü sahibi şair” olarak tanınır. Kendisi Einstein’ın bile fikirlerinden…
Yunan matematiğinin altın çağının en önemli isimlerinden biri olan Pergeli Apollonius, Arşimet ve Öklid ile birlikte anılmayı hak eden bir…
Matematikte ilginç isimli teoremler sıklıkla karşımıza çıkar. Bunlardan bir tanesi de Pizza teoremidir. Pizza teoremi hakkında bilgi vermeden önce süreci…